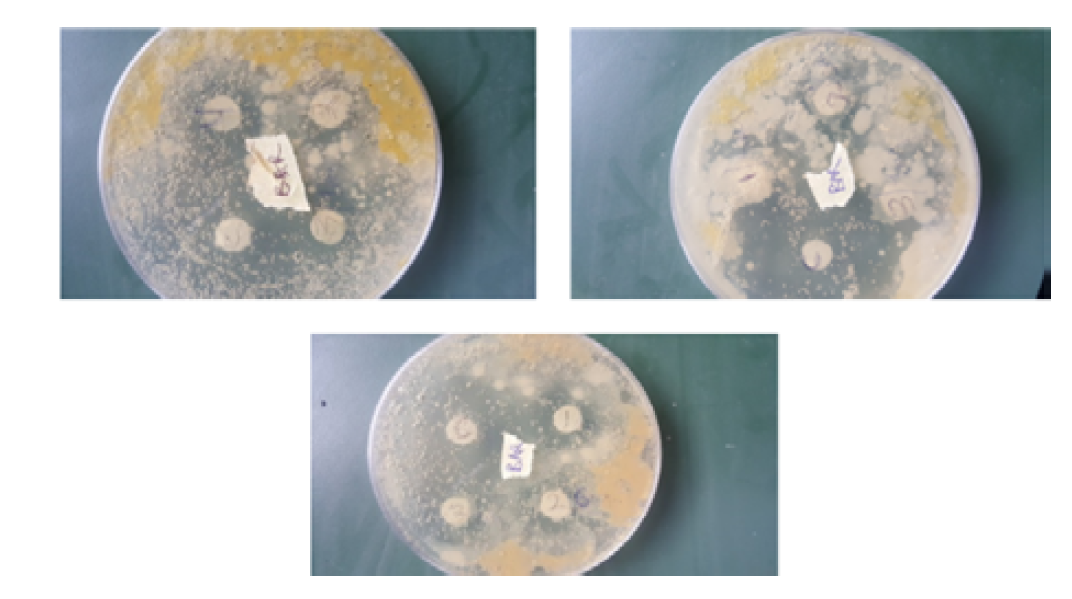
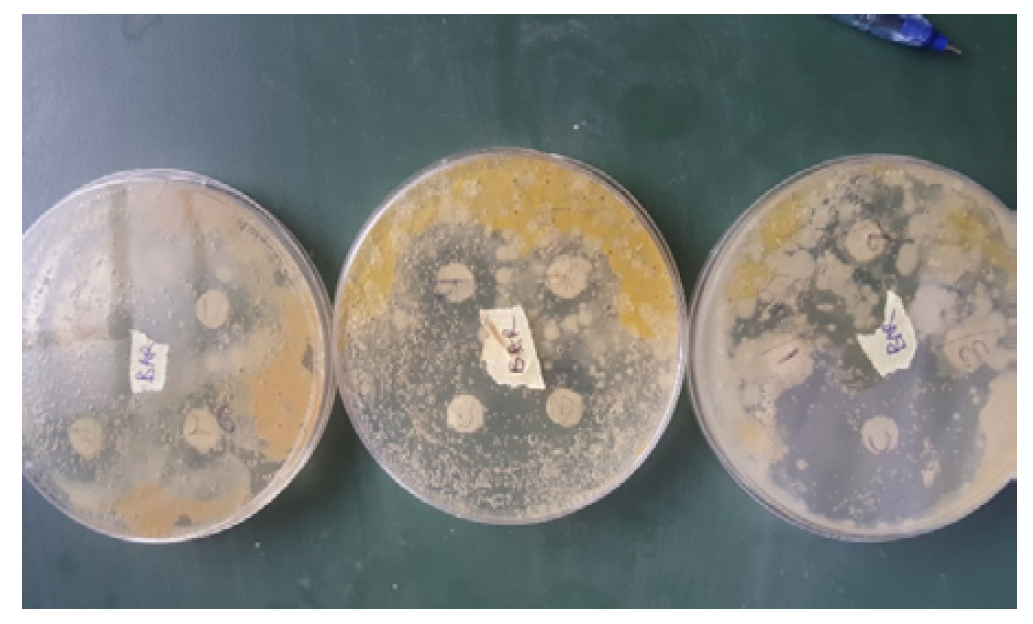

Sample Collection
The tested drugs Mectizan (Ivermectin) and Ampiclox (a positive control) were both gotten from a pharmaceutical store for the susceptibility test. Mectizan was one of the drugs used during the early part of the pandemic outbreak (COVID-19) and touted as a possible cure.
Sterilization
Glass wares were sterilized in an autoclave. Autoclave chamber water level was checked, then, switched on and the valve opened after 15 minutes, before the valve was closed to allow the gauge to rise to 121oC [6]. Glass wares were removed after being sterilized.
Microorganisms Used
Clinical identified Oral bacteria, Staphylococcus aureus, Bacillus cereus, Citrobacter freundi and Enterobacter sp. were obtained from a preserved culture obtained from a recent work. These organisms were re-cultured to obtain a pure culture and were inoculated each into a prepared nutrient Agar, before the impregnation of the tested drugs and incubated at 370C for the susceptibility testing.
Preparation of Sample
Preparation of Drug on Disc: The drug dose difference (3, 6 and 9mg) as recommended per patients was not exceeded. Thus; 3mg/mL, 6mg/mL and 9mg/mL of Mectizan was impregnated on the tested organism and compared with the standard prescribed dose of the positive control (500mg). The dose difference was tested with each of the oral pathogens Staphylococcus aureus, Bacillus cereus, Citrobacter freundi and Enterobacter sp.
Preparation of Antibiotic (Positive Control) Disc
The antibiotic used as control was Ampiclox (500mg), for respective bacterial as positive control. The discs were also gotten from whatman No.1 filter paper with size 6mm in diameter borer. The Ampiclox was dissolve in 1mL of deionized water to obtain a dilution and impregnated in quadruplet. All the discs were allowed to dry. The dishes were transferred aseptically to already set media containing the pathogenic microorganism. The essence of the control is to determine the degree at which the drug concentration inhibits the growth of the clinically isolated organisms [7].
Preparation of Filter Paper Discs
An oven sterilized cork borer (6mm) was used to cut uniform discs’ sizes from a Whatman Grade 1 filter paper. The cut discs were put into a Petri-dish plate and were sterilized for use, following standard techniques [6]. The discs were sterilized in hot air Oven at 1800C for 1 hour, after which they were allowed to cool with slight modification.
Preparation of Media
The primary media employed were nutrient agar (NA). All media were prepared according to manufacturer’s specification. Based on manufacturers instruction; 28g of nutrient Agar to 1000mL of distilled water. For 12 Petri-dishes, requires 6.7g of nutrient Agar into 240mL of distilled water. Therefore, 6.7g of nutrient Agar was weighed into 240mL of distilled water in a conical flask, well shaken, covered with aluminum foil and autoclaved.
Antimicrobial Susceptibility Testing
Susceptibility was determined using Agar disc diffusion method as described by Adeniyi et al, [8], Adenipekun et al. [9], Kigigha and Atuzie, [7]. Already set nutrient agar plates were inoculated aseptically with the serial dilution containing each of the test organisms and allowed to stand for 30 minutes, each of the plates were labeled appropriately with each test organism to avoid mix up. The impregnated disc containing each of the extracts was now placed aseptically on the respective media in quadruplicates using sterile forceps. The impregnated discs were well spaced on the confluent growth of the test organisms to prevent their zone of inhibition from over lapping. The inoculated nutrient agar plates were incubated for 24hour at 370C. Following incubation, the diameter of the zone of inhibition were measured with a ruler in millimeters (mm) and recorded.
Data Analysis
The means and standard deviations were calculated for all inhibitory values of mectazin doses and control. Analysis of variance (ANOVA) was employed to determine statistical differences and similarities between means at the 95% confidence limit. Turkey HSD Post HOC test was used to separate means and locate where the differences exist. This was aided by the use of SPSS® 20.0 statistical tool kit.